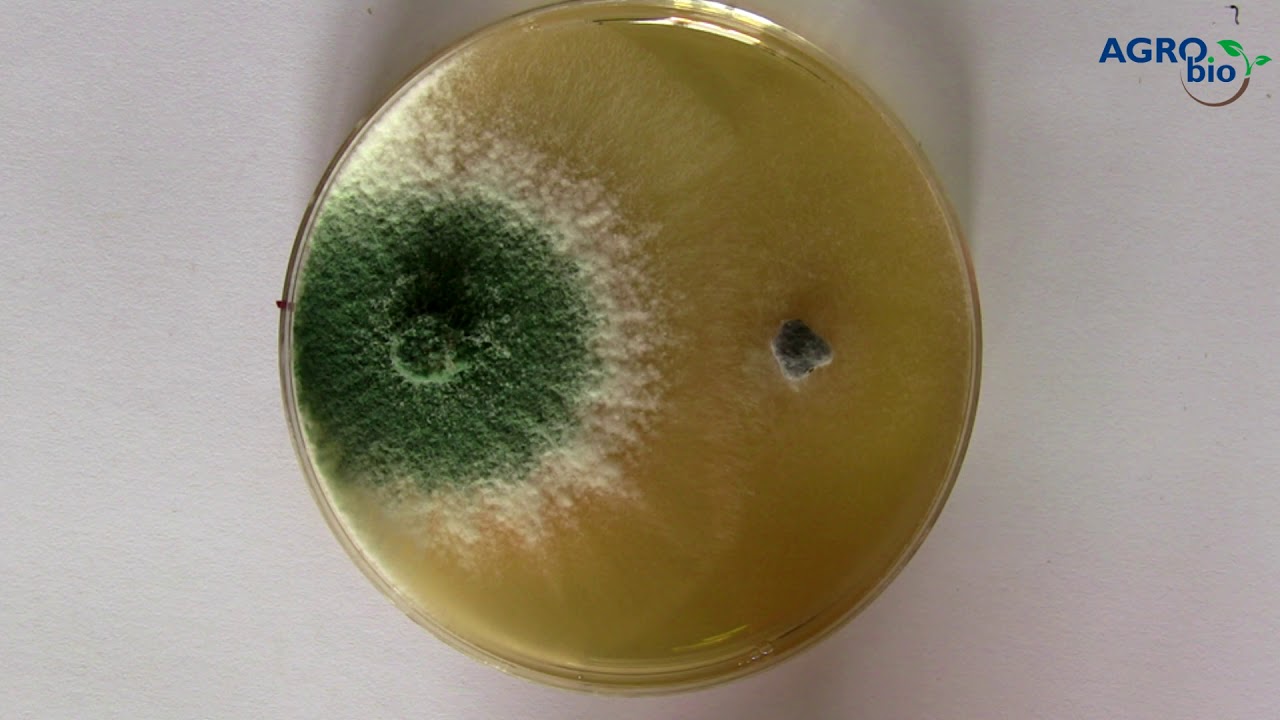

TrichoMAX - trichoderma gomba
Ingyenes tanácsadásért keresse szakértőinket:
Tel.: +36 94 313 609
Email:

Különösen silókukorica esetében érdemes a BactoFil Kukorica és az Algafix hatását a TrichoMax termékkel tovább erősíteni. A biokontroll hatású TrichoMax minimálisra csökkenti a toxintermelő gombák fertőzési nyomását, ezáltal a haszonállatok egészséges, toxinmentes takarmányhoz jutnak.
Ha az elmúlt 8 év során volt napraforgó a területen, és szeretnénk elkerülni a Sclerotinia és a Macrophomina károsítását, akkor feltétlenül érdemes vetés előtt TrichoMax-szal kezelni a táblát. Ez a termék hatékony mikrobiológiai támogatást biztosít a fertőzési nyomás csökkentésével és a növény ellenálló képességének növelésével.
A Trichoderma harzianum hiperparazita hasznos gombát tartalmazó készítmény. Összetett hatásával az egész vegetáció során segíti a kultúrnövények egészséges fejlődését, így biztosítva a magasabb terméshozam és a jobb minőség lehetőségét.
Bármely kultúrában alkalmazható mikrobiológiai termék, amely hatékonyan támogatja a gombaölő szerek hatását a fertőzések kialakulásának csökkentésével.
Felhasználás
Valamennyi szántóföldi és kertészeti kultúrában 1–2,5 kg/ha dózisban alkalmazható, a vetés előtti talaj előkészítéskor a talajra kijuttatva, majd a talajba bedolgozva. Állományban öntözőberendezéssel a talajba juttatva.
Fungicid hatású növényvédő szerekkel és talajfertőtlenítőkkel együtt nem alkalmazható!